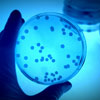

Impressum
Angaben gemäß § 5 TMG
Christian Kniele
CK Innovative Gebäudetechnik
Burgfriedenstr. 14
86316 Friedberg
Kontakt
Telefon: +49 (0) 8214306151
Telefax: +49 (0) 8214309108
E-Mail:
Umsatzsteuer-ID
Umsatzsteuer-Identifikationsnummer gemäß § 27 a Umsatzsteuergesetz:
DE216177802
Aufsichtsbehörde
IHK Industrie- und Handelskammer Augsburg
Stettenstr. 1 + 3
86150 Augsburg
Berufsbezeichnung und berufsrechtliche Regelungen
Berufsbezeichnung: Dipl-Ing.(FH) Versorgungstechnik für Heizungs-, Klima-, Lüftungs- und Sanitärtechnik
Zert. Sachverständiger VDI DVGW 6023 Kat. A
Dozent HWK für Schwaben
Zuständige Kammer:
IHK Industrie- und Handelskammer Augsburg
Stettenstr. 1 + 3
86150 Augsburg
HWK Handwerkskammer für Schwaben
Siebentischstr. 52-58
86161 Augsburg
Verliehen in: Deutschland
Es gelten folgende berufsrechtliche Regelungen:
Regelungen einsehbar unter: https://www.gesetze-im-internet.de/hwo/index.html
Angaben zur Berufshaftpflichtversicherung
Name und Sitz des Versicherers:
Nürnberger Allgemeine Versicherungs-AG
90334 Nürnberg
Geltungsraum der Versicherung:
Deutschland
Redaktionell verantwortlich
Christian Kniele
Burgfriedenstr. 14
86316 Friedberg
EU-Streitschlichtung
Die Europäische Kommission stellt eine Plattform zur Online-Streitbeilegung (OS) bereit: https://ec.europa.eu/consumers/odr/.
Unsere E-Mail-Adresse finden Sie oben im Impressum.
Verbraucherstreitbeilegung/Universalschlichtungsstelle
Wir sind nicht bereit oder verpflichtet, an Streitbeilegungsverfahren vor einer Verbraucherschlichtungsstelle teilzunehmen. © Paylessimages / Fotolia
© Paylessimages / Fotolia © F - stock.adobe.com
© F - stock.adobe.com © F - stock.adobe.com
© F - stock.adobe.com © Shawn Hempel - stock.adobe.com
© Shawn Hempel - stock.adobe.com © dusanpetkovic1 - stock.adobe.com
© dusanpetkovic1 - stock.adobe.com © romaset - stock.adobe.com
© romaset - stock.adobe.com © serhii Moiseiev - stock.adobe.com
© serhii Moiseiev - stock.adobe.com © djoronimo - stock.adobe.com
© djoronimo - stock.adobe.com © jozsitoeroe - stock.adobe.com
© jozsitoeroe - stock.adobe.com © Looker_Studio - stock.adobe.com
© Looker_Studio - stock.adobe.com © cassis - stock.adobe.com
© cassis - stock.adobe.com © luchschen: luchschen - stock.adobe.com
© luchschen: luchschen - stock.adobe.com © victor zastol'skiy - stock.adobe.com
© victor zastol'skiy - stock.adobe.com © PETER BOCKLANDT
© PETER BOCKLANDT  © Oliver Boehmer - bluedesign®
© Oliver Boehmer - bluedesign® © stock.adobe.com
© stock.adobe.com © F - stock.adobe.com
© F - stock.adobe.com © dusanpetkovic1 - stock.adobe.com
© dusanpetkovic1 - stock.adobe.com © Goodvibes Photo - stock.adobe.com
© Goodvibes Photo - stock.adobe.com © Hersteller
© Hersteller © peterschreiber.media - stock.adobe.com
© peterschreiber.media - stock.adobe.com © stock.adobe.com
© stock.adobe.com © drazen_zigic - stock.adobe.com
© drazen_zigic - stock.adobe.com
Haftung für Inhalte
Als Diensteanbieter sind wir gemäß § 7 Abs.1 TMG für eigene Inhalte auf diesen Seiten nach den allgemeinen Gesetzen verantwortlich. Nach §§ 8 bis 10 TMG sind wir als Diensteanbieter jedoch nicht verpflichtet, übermittelte oder gespeicherte fremde Informationen zu überwachen oder nach Umständen zu forschen, die auf eine rechtswidrige Tätigkeit hinweisen.
Verpflichtungen zur Entfernung oder Sperrung der Nutzung von Informationen nach den allgemeinen Gesetzen bleiben hiervon unberührt. Eine diesbezügliche Haftung ist jedoch erst ab dem Zeitpunkt der Kenntnis einer konkreten Rechtsverletzung möglich. Bei Bekanntwerden von entsprechenden Rechtsverletzungen werden wir diese Inhalte umgehend entfernen.
Haftung für Links
Unser Angebot enthält Links zu externen Websites Dritter, auf deren Inhalte wir keinen Einfluss haben. Deshalb können wir für diese fremden Inhalte auch keine Gewähr übernehmen. Für die Inhalte der verlinkten Seiten ist stets der jeweilige Anbieter oder Betreiber der Seiten verantwortlich. Die verlinkten Seiten wurden zum Zeitpunkt der Verlinkung auf mögliche Rechtsverstöße überprüft. Rechtswidrige Inhalte waren zum Zeitpunkt der Verlinkung nicht erkennbar.
Eine permanente inhaltliche Kontrolle der verlinkten Seiten ist jedoch ohne konkrete Anhaltspunkte einer Rechtsverletzung nicht zumutbar. Bei Bekanntwerden von Rechtsverletzungen werden wir derartige Links umgehend entfernen.
Urheberrecht
Die durch die Seitenbetreiber erstellten Inhalte und Werke auf diesen Seiten unterliegen dem deutschen Urheberrecht. Die Vervielfältigung, Bearbeitung, Verbreitung und jede Art der Verwertung außerhalb der Grenzen des Urheberrechtes bedürfen der schriftlichen Zustimmung des jeweiligen Autors bzw. Erstellers. Downloads und Kopien dieser Seite sind nur für den privaten, nicht kommerziellen Gebrauch gestattet.
Soweit die Inhalte auf dieser Seite nicht vom Betreiber erstellt wurden, werden die Urheberrechte Dritter beachtet. Insbesondere werden Inhalte Dritter als solche gekennzeichnet. Sollten Sie trotzdem auf eine Urheberrechtsverletzung aufmerksam werden, bitten wir um einen entsprechenden Hinweis. Bei Bekanntwerden von Rechtsverletzungen werden wir derartige Inhalte umgehend entfernen.
Quelle: https://www.e-recht24.de
